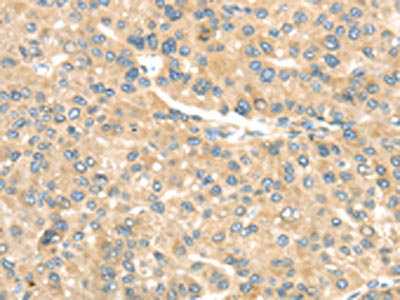

TRAK1 Antibody
-
中文名稱:TRAK1兔多克隆抗體
-
貨號:CSB-PA999701
-
規(guī)格:¥1100
-
圖片:
-
其他:
產(chǎn)品詳情
-
Uniprot No.:
-
基因名:TRAK1
-
別名:TRAK1 antibody; KIAA1042 antibody; OIP106 antibody; Trafficking kinesin-binding protein 1 antibody; 106 kDa O-GlcNAc transferase-interacting protein antibody; Protein Milton antibody
-
宿主:Rabbit
-
反應(yīng)種屬:Human
-
免疫原:Fusion protein of Human TRAK1
-
免疫原種屬:Homo sapiens (Human)
-
標(biāo)記方式:Non-conjugated
-
抗體亞型:IgG
-
純化方式:Antigen affinity purification
-
濃度:It differs from different batches. Please contact us to confirm it.
-
保存緩沖液:-20°C, pH7.4 PBS, 0.05% NaN3, 40% Glycerol
-
產(chǎn)品提供形式:Liquid
-
應(yīng)用范圍:ELISA,IHC
-
推薦稀釋比:
Application Recommended Dilution ELISA 1:2000-1:5000 IHC 1:25-1:100 -
Protocols:
-
儲存條件:Upon receipt, store at -20°C or -80°C. Avoid repeated freeze.
-
貨期:Basically, we can dispatch the products out in 1-3 working days after receiving your orders. Delivery time maybe differs from different purchasing way or location, please kindly consult your local distributors for specific delivery time.
-
用途:For Research Use Only. Not for use in diagnostic or therapeutic procedures.
相關(guān)產(chǎn)品
靶點詳情
-
功能:Involved in the regulation of endosome-to-lysosome trafficking, including endocytic trafficking of EGF-EGFR complexes and GABA-A receptors. Involved in mitochondrial motility. When O-glycosylated, abolishes mitochondrial motility. Crucial for recruiting OGT to the mitochondrial surface of neuronal processes. TRAK1 and RHOT form an essential protein complex that links KIF5 to mitochondria for light chain-independent, anterograde transport of mitochondria.
-
基因功能參考文獻:
- Data show that the ADP-ribosylation factor 6 (Arf6)-trafficking kinesin protein 1 (trak1) promote the anterograde trafficking of mitochondria. PMID: 29992963
- This study confirms the role of TRAK1 in mitochondrial dynamics and constitutes the first report of this gene in association with a severe neurodevelopmental disorder. PMID: 28364549
- This study showed that the TRAK1 was prevalently localized in axons of hippocampal and cortical neurons. PMID: 25653102
- Data suggest that vitamin D receptor target genes (TRAK1; DUSP10, dual specificity phosphatase 10; NRIP1, nuclear receptor interacting protein 1; THBD, thrombomodulin) can be used as markers for individual's response to vitamin D3 supplements. PMID: 24975273
- By mapping and mutating four key sites of GlcNAc addition in hMilton1 (hMilton1Qmut), study demonstrated that Milton is the key and essential substrate through which OGT inhibits mitochondrial motility. PMID: 24995978
- Details of a robust association of DISC1 with mitochondrial transport complexes containing TRAK1 and Miro1. PMID: 24092329
- The results of this study established a key role for mammalian TRAK1 proteins in axonal and dendritic targeting of mitochondria. PMID: 23395375
- MGb2-Ag/TRAK1 may play an important role in the development of colorectal cancer (CRC) and may be a valuable prognostic indicator of CRC. PMID: 21573901
- GRIF-1 and OIP106 have roles in protein and/or organelle transport in excitable cells in a manner analogous to glutamate receptor-interacting-protein 1 PMID: 15644324
- Data show that Trak1 interacts with hepatocyte-growth-factor-regulated tyrosine kinase substrate (Hrs), an essential component of the endosomal sorting and trafficking machinery. PMID: 18675823
- TRAK1/MGb2-Ag is a promising diagnostic marker for gastric cancer and may help to detect signet-ring cell carcinoma and mucinous adenocarcinoma PMID: 18986759
顯示更多
收起更多
-
亞細(xì)胞定位:Cytoplasm. Nucleus. Mitochondrion. Early endosome. Endosome. Mitochondrion membrane. Cytoplasm, cell cortex.
-
組織特異性:High expression in spinal cord and moderate expression in all other tissues and specific brain regions examined. Expressed in all cell lines examined.
-
數(shù)據(jù)庫鏈接:
Most popular with customers
-
-
YWHAB Recombinant Monoclonal Antibody
Applications: ELISA, WB, IHC, IF, FC
Species Reactivity: Human, Mouse, Rat
-
-
-
-
-
-